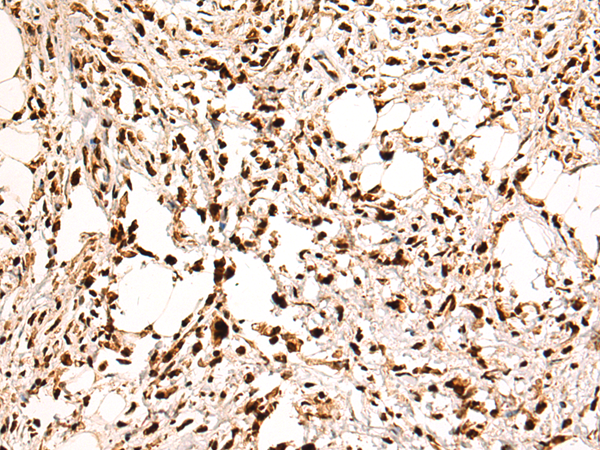
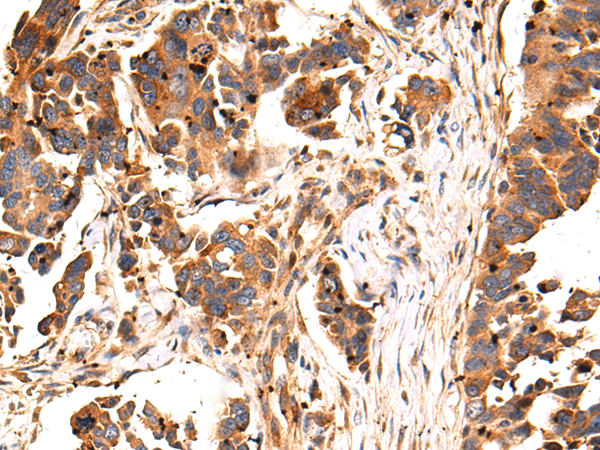
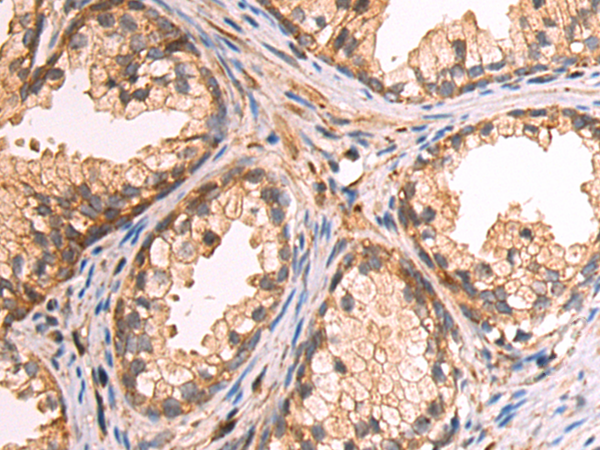
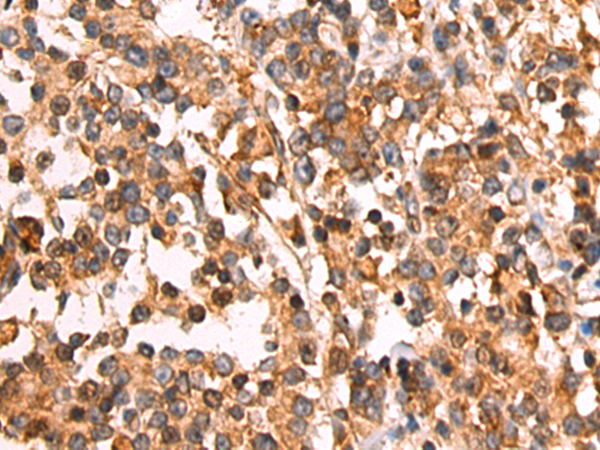
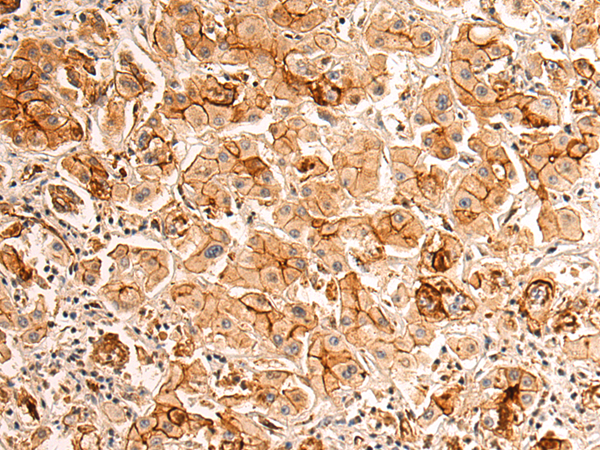
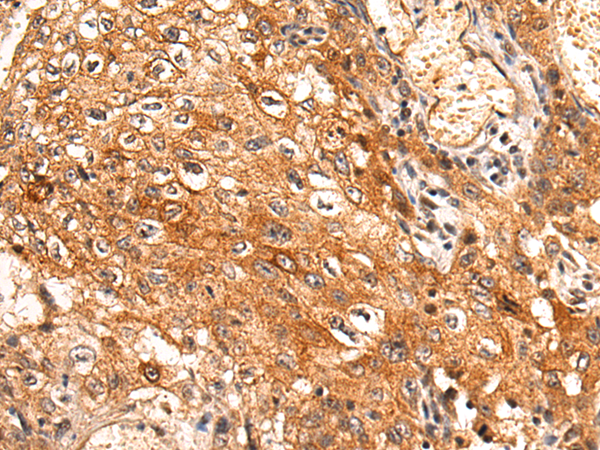

-
分类: 科研抗体货号: P10559别名: nPTB; PTBLP; brPTB应用: WB,IHC反应种属: Human, Mouse, Rat
-
分类: 科研抗体货号: P10541别名: STCH应用: WB,IHC反应种属: Human, Mouse, Rat
-
分类: 科研抗体货号: P10553别名: ALO17; MYMY2; MYSTR; NET57; C17orf27; KIAA1618应用: IHC反应种属: Human
-
分类: 科研抗体货号: P10558别名: NOP5; HSPC120; NOP5/NOP58应用: WB,IHC反应种属: Human, Mouse, Rat
-
分类: 科研抗体货号: P10539别名: E2-230K应用: IHC反应种属: Human, Mouse, Rat
-
分类: 科研抗体货号: P10552别名:应用: WB反应种属: Human, Mouse, Rat
-
分类: 科研抗体货号: P10538别名: RNF93; ZNFB7; ZNF178应用: IHC反应种属: Human
-
分类: 科研抗体货号: P10557别名: PUS9; C18B11; C15orf19应用: WB,IHC反应种属: Human
-
分类: 科研抗体货号: P10551别名: hT41; C8orf1应用: IHC反应种属: Human
-
分类: 科研抗体货号: P10565别名: PALML; C1orf11应用: IHC反应种属: Human, Mouse, Rat

鄂公网安备42018502007531号
鄂公网安备42018502007531号

